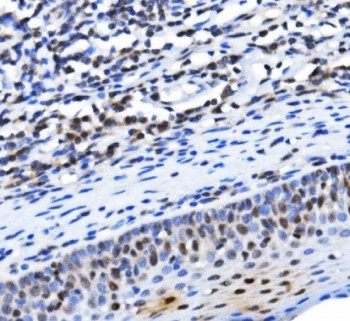
Anti-TBP associated factor 4 / TAF4

Cookie-Einstellungen
Diese Website benutzt Cookies, die für den technischen Betrieb der Website erforderlich sind und stets gesetzt werden. Andere Cookies, die den Komfort bei Benutzung dieser Website erhöhen, der Direktwerbung dienen oder die Interaktion mit anderen Websites und sozialen Netzwerken vereinfachen sollen, werden nur mit Ihrer Zustimmung gesetzt.
Konfiguration
Technisch erforderlich
Diese Cookies sind für die Grundfunktionen des Shops notwendig.
"Alle Cookies ablehnen" Cookie
"Alle Cookies annehmen" Cookie
Ausgewählter Shop
CSRF-Token
Cookie-Einstellungen
FACT-Finder Tracking
Individuelle Preise
Kundenspezifisches Caching
Session
Währungswechsel
Komfortfunktionen
Diese Cookies werden genutzt um das Einkaufserlebnis noch ansprechender zu gestalten, beispielsweise für die Wiedererkennung des Besuchers.
Facebook-Seite in der rechten Blog - Sidebar anzeigen
Merkzettel
Statistik & Tracking
Endgeräteerkennung
Kauf- und Surfverhalten mit Google Tag Manager
Partnerprogramm
| Artikelnummer | Größe | Datenblatt | Manual | SDB | Lieferzeit | Menge | Preis |
|---|---|---|---|---|---|---|---|
| NSJ-RQ6398 | 100 µg | - | - |
3 - 10 Werktage* |
790,00 €
|
Bei Fragen nutzen Sie gerne unser Kontaktformular.
Bestellen Sie auch per E-Mail: info@biomol.com
Größere Menge gewünscht? Bulk-Anfrage
Bestellen Sie auch per E-Mail: info@biomol.com
Größere Menge gewünscht? Bulk-Anfrage
0.5mg/ml if reconstituted with 0.2ml sterile DI water. Transcription initiation factor TFIID... mehr
Produktinformationen "Anti-TBP associated factor 4 / TAF4"
0.5mg/ml if reconstituted with 0.2ml sterile DI water. Transcription initiation factor TFIID subunit 4 is a protein that in humans is encoded by the TAF4 gene. Initiation of transcription by RNA polymerase II requires the activities of more than 70 polypeptides. The protein that coordinates these activities is transcription factor IID (TFIID), which binds to the core promoter to position the polymerase properly, serves as the scaffold for assembly of the remainder of the transcription complex, and acts as a channel for regulatory signals. TFIID is composed of the TATA-binding protein (TBP) and a group of evolutionarily conserved proteins known as TBP-associated factors or TAFs. TAFs may participate in basal transcription, serve as coactivators, function in promoter recognition or modify general transcription factors (GTFs) to facilitate complex assembly and transcription initiation. This gene encodes one of the larger subunits of TFIID that has been shown to potentiate transcriptional activation by retinoic acid, thyroid hormone and vitamin D3 receptors. In addition, this subunit interacts with the transcription factor CREB, which has a glutamine-rich activation domain, and binds to other proteins containing glutamine-rich regions. Aberrant binding to this subunit by proteins with expanded polyglutamine regions has been suggested as one of the pathogenetic mechanisms underlying a group of neurodegenerative disorders referred to as polyglutamine diseases. Protein function: Part of the TFIID complex, a multimeric protein complex that plays a central role in mediating promoter responses to various activators and repressors. Potentiates transcriptional activation by the AF-2S of the retinoic acid, vitamin D3 and thyroid hormone. [The UniProt Consortium]
| Schlagworte: | Anti-TAF4, Anti-TAF2C, Anti-TAFII130, Anti-TAFII135, Anti-TAFII-130, Anti-TAFII-135, Anti-TAF(II)130, Anti-TAF(II)135, Anti-TBP-associated factor 4, Anti-Transcription initiation factor TFIID subunit 4, TBP associated factor 4 Antibody / TAF4 |
| Hersteller: | NSJ Bioreagents |
| Hersteller-Nr: | RQ6398 |
Eigenschaften
| Anwendung: | WB, IHC (paraffin), IF, FC, Direct ELISA |
| Antikörper-Typ: | Polyclonal |
| Konjugat: | No |
| Wirt: | Rabbit |
| Spezies-Reaktivität: | human, mouse, rat |
| Immunogen: | Recombinant human protein (amino acids D6-K1085) |
| Format: | Purified |
Datenbank Information
| KEGG ID : | K03129 | Passende Produkte |
| UniProt ID : | O00268 | Passende Produkte |
| Gene ID : | GeneID 6874 | Passende Produkte |
Handhabung & Sicherheit
| Lagerung: | +4°C |
| Versand: | +4°C (International: +4°C) |
Achtung
Nur für Forschungszwecke und Laboruntersuchungen: Nicht für die Anwendung im oder am Menschen!
Nur für Forschungszwecke und Laboruntersuchungen: Nicht für die Anwendung im oder am Menschen!
Hier folgen Informationen zur Produktreferenz.
mehr
Hier kriegen Sie ein Zertifikat
Loggen Sie sich ein oder registrieren Sie sich, um Analysenzertifikate anzufordern.
Bewertungen lesen, schreiben und diskutieren... mehr
Kundenbewertungen für "Anti-TBP associated factor 4 / TAF4"
Bewertung schreiben
Loggen Sie sich ein oder registrieren Sie sich, um eine Produktbewertung abzugeben.
Zuletzt angesehen